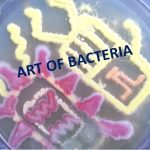
Microbial Art: Microbial art or agar art or germ art  is the same thing  in which  artwork created by culturing microorganisms in certain patterns. The microbes used can be bacteria, yeast fungi, or  protists (less commonly). The microbes can be chosen for their natural colors. Organisms most commonly used  and available are Staphylococcus aureus, Pseudomonas aeruginosa , Serratia marcescens as shown above picture. Painting with bacteria isn’t entirely new because Sir Alexander Fleming, the scientist responsible for discovering penicillin in the 1920s, began making “germ paintings” of bacteria during his career as a microbiologist. Similarly,Roger Tsien  (biochemist) won the 2008 Nobel prize in  chemistry for his contributions to knowledge of green fluorescent protein (GFP) and using this GFP, Nathan Shaner (researcher) made a 2006 microbial artwork of a San Diego beach scene.

Collection Group: Clinical Bacteriology
Pus Having Streptococcus pyogenes: Introduction and its Gram Stain
 Streptococcus pyogenes in Pus Pus having Streptococcus pyogenes as shown above...
Streptococcus pyogenes in Pus Pus having Streptococcus pyogenes as shown above...
Streptococcus pneumoniae in Sputum: Introduction, Principle, Procedure and Result Interpretation
 Introduction Streptococcus pneumoniae gram stain of sputum as shown above...
Introduction Streptococcus pneumoniae gram stain of sputum as shown above...
Microbial Art: Introduction, Requirements, Making Procedure and Uses
Introduction of Microbial Art Microbial art or agar art or...
Introduction of Microbial Art Microbial art or agar art or...
